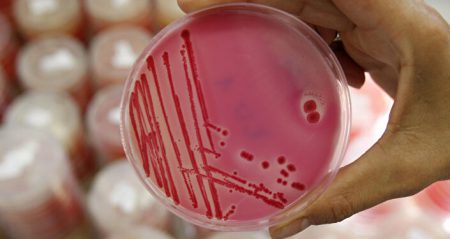

ABD’de salmonella salgını: ‚Tavukları öpmeyin‘
ABD Hastalık Kontrol ve Korunma Merkezleri, ülkede görülen salmonella salgını nedeniyle halka canlı tavuk öpmeyin dedi.
“TAVUKLARI ÖPMEYİN ONLARA SARILMAYIN”
Yapılan açıklamada, „Tavukları öpmeyin veya onlara sarılmayın. Ağzınızdan mikrop bulaşabilir ve hastalanabilirsiniz“ denildi.
Sputnik’te yer alan habere göre; uyarıda tavuk ve ördek gibi kümes hayvanları temiz görülseler de hastalık taşıyabilecekleri belirtildi.
Salmonellanın belirtileri arasında ateş, ishali, karın ağrısı ve kusma bulunuyor. Çoğu insan hastalığı tedavi görmeden atlatsa da, bazı ağır vakalar ölüm ile sonuçlanabiliyor. ABD’de şubat ayından bu yana 34 kişinin salmonella nedeniyle hastaneye kaldırıldığı ancak ölüm yaşanmadığı belirtildi.
ABD’de çiğ etlerde çıkan Salmonella bakterisi nedeniyle 26 eyalette 246 vakaya rastlandı. Salgından etkilenen 2 bin tondan fazla etin imha edilmesi çağrısında bulunuldu.
ABD Gıda Güvenliği ve Denetleme Dairesi, ülkedeki Salmonella bakterisi salgını nedeniyle 26 eyalette 246 kişinin rahatsızlandığını açıkladı. Yaklaşık 2 bin tondan fazla çiğ etin bakteriden etkilendiği ancak ne kadarının satıldığı ve ne kadarının hala marketlerde satışta olduğunun ise bilinmediği belirtildi.
Bakteriden etkilenen ürünlerin, 26 Temmuz-7 Eylül arasında Arizona’daki JBS Tolleson adlı tesiste üretilip, paketlendiği bildirildi.
Marketlere üretim bilgileri uyan etlerin imha edilmesi, halka da söz konusu etlerin satın alındığının fark edilmesi durumunda tüketilmemesi çağrısında bulunuldu.
ABD’de ekim başında bakteri nedeniyle yaklaşık 3 bin ton çiğ et dağıtımdan çekilmişti. O dönem açıklanan verilerde, 16 eyalette 60 kişinin bakteri nedeniyle hastalandığı belirtilmişti.
Bağırsak sistemini etkileyen Salmonella bakterisi, vücut direncini düşürerek ishal, ateş ve kusmaya neden oluyor. Bakteri, su veya dışkı teması gerçekleşmiş gıdaların tüketilmesiyle insanlara bulaşabiliyor.
Uzmanlar, bakteriyi yok etmek için özellikle tavuk gibi gıdaların yüksek ısıda en az 10 dakika pişirilmesini öneriyor.



















